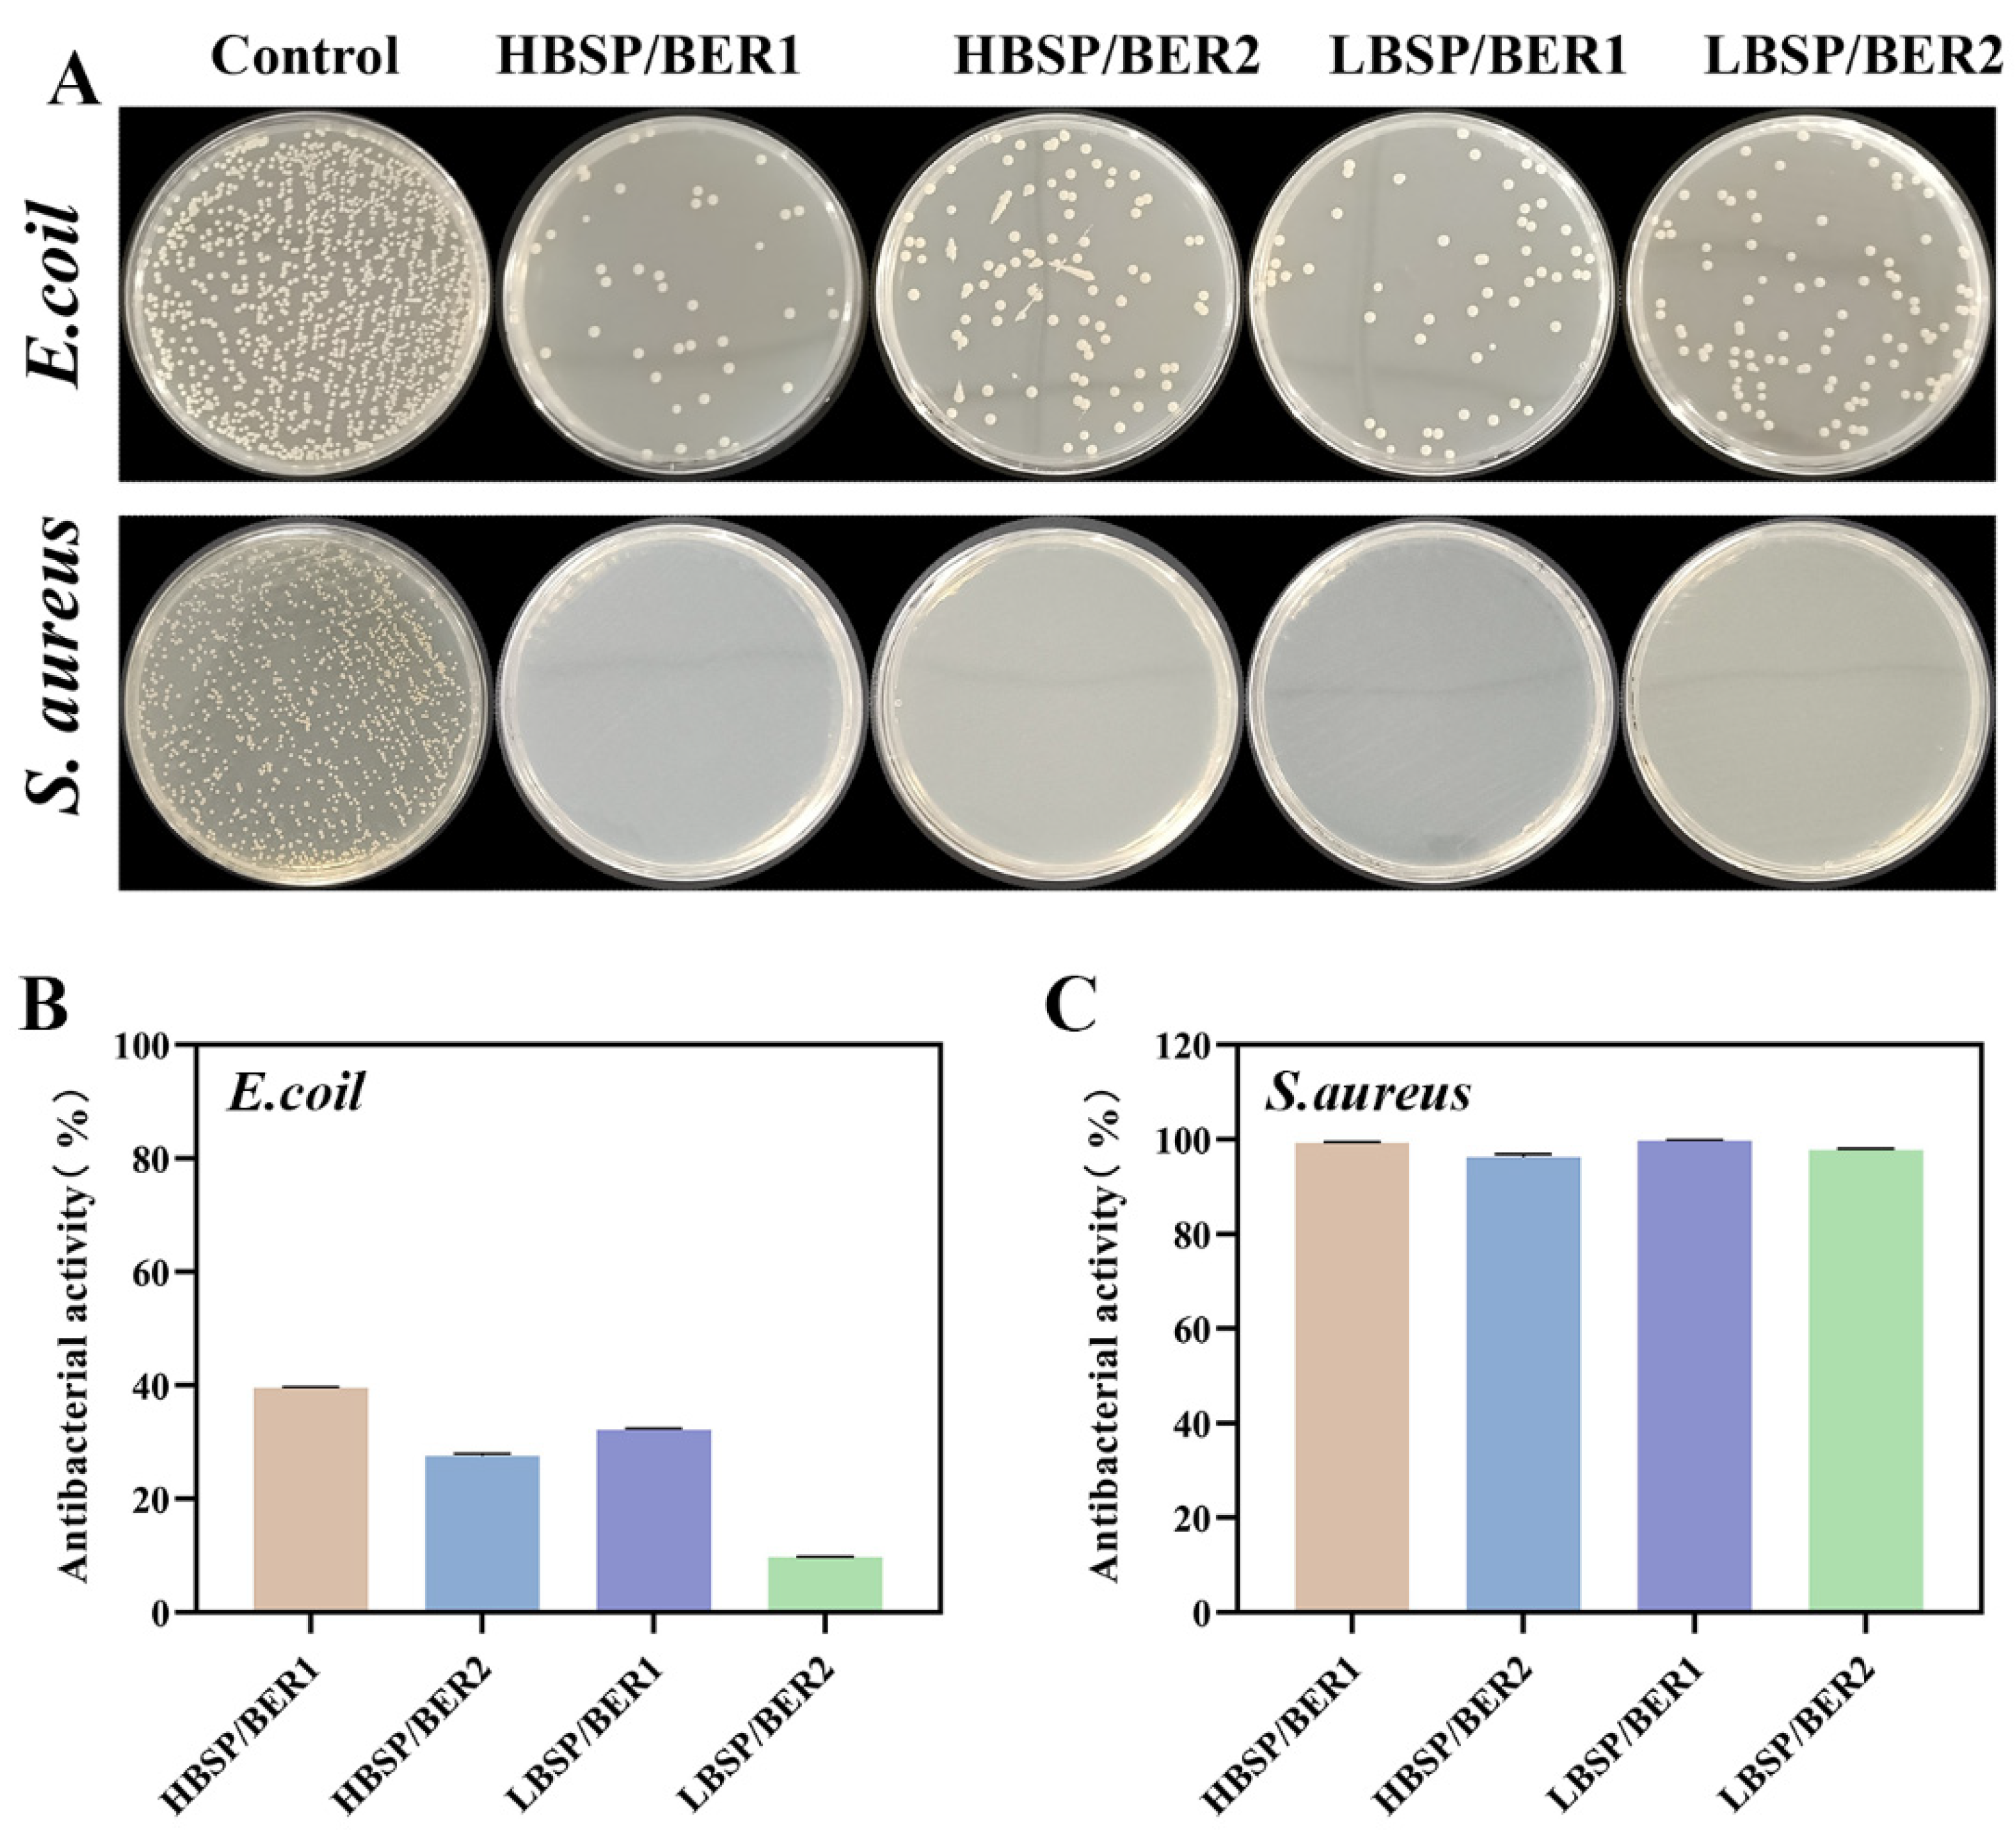
Ijms 24 16286 g005

A Berberine-Loaded Bletilla striata Polysaccharide Hydrogel as a New Medical Dressing for Diabetic Wound Healing
Abstract
:1. Introduction
2. Results and Discussion
2.1. Characterizations of BSP/BER Hydrogel
2.2. Biocompatibility of BSP/BER Hydrogel
2.3. Glucose Consumption and Migration Experiment
2.4. Antioxidant and Anti-Inflammation Properties of Hydrogel
2.5. Antibacterial Properties of BSP/BER Hydrogel
2.6. In Vivo Diabetic Wound Healing
3. Materials and Methods
3.1. Materials
3.2. Synthesis of BSP/BER Hydrogel
3.3. Characterization of BSP/BER Hydrogel
3.3.1. Scanning Electron Microscopy (SEM)
3.3.2. Fourier Transform Infrared Spectroscopy (FTIR)
3.3.3. Viscosity and Rheology Characteristics of Hydrogel
3.3.4. Water Loss Rate
3.3.5. BER Release Behavior from Hydrogel
3.4. In Vitro Assessments
3.4.1. Cell Culture
3.4.2. Cytocompatibility Experiments
3.4.3. Hemolysis Assessment
3.4.4. Determination of Cellular Glucose Consumption
3.4.5. Cell Migration Assay
3.4.6. Antioxidant Properties Assay
3.4.7. Anti-Inflammatory Activity Assay
3.4.8. Antibacterial Activity Assay
3.5. In Vivo Assessments
3.5.1. Diabetic Chronic Wound Healing Assay
3.5.2. Histopathological Evaluation
3.6. Statistical Assay
4. Conclusions
Author Contributions
Funding
Institutional Review Board Statement
Informed Consent Statement
Data Availability Statement
Acknowledgments
Conflicts of Interest
References
- Zhao, Y.; Pan, B.; Lv, X.; Chen, C.; Li, K.; Wang, Y.; Liu, J. Ferroptosis: Roles and molecular mechanisms in diabetic cardiomyopathy. Front. Endocrinol. 2023, 14, 1140644. [Google Scholar] [CrossRef] [PubMed]
- Tan, C.T.; Liang, K.; Ngo, Z.H.; Dube, C.T.; Lim, C.Y. Application of 3D Bioprinting Technologies to the Management and Treatment of Diabetic Foot Ulcers. Biomedicines 2020, 8, 441. [Google Scholar] [CrossRef] [PubMed]
- Wang, Y.; Pi, Y.; Hu, L.; Peng, Z.; Hu, H.; Zhao, J.; Zhou, Y.; Wang, D. Proteomic analysis of foot ulcer tissue reveals novel potential therapeutic targets of wound healing in diabetic foot ulcers. Comput. Biol. Med. 2023, 159, 106858. [Google Scholar] [CrossRef]
- McDermott, K.; Fang, M.; Boulton, A.J.M.; Selvin, E.; Hicks, C.W. Etiology, Epidemiology, and Disparities in the Burden of Diabetic Foot Ulcers. Diabetes Care 2023, 46, 209–221. [Google Scholar] [CrossRef]
- Yammine, K.; Hayek, F.; Assi, C. A meta-analysis of mortality after minor amputation among patients with diabetes and/or peripheral vascular disease. J. Vasc. Surg. 2020, 72, 2197–2207. [Google Scholar] [CrossRef]
- Armstrong, D.G.; Swerdlow, M.A.; Armstrong, A.A.; Conte, M.S.; Padula, W.V.; Bus, S.A. Five year mortality and direct costs of care for people with diabetic foot complications are comparable to cancer. J. Foot Ankle Res. 2020, 13, 16. [Google Scholar] [CrossRef]
- Li, X.; Jing, X.; Yu, Z.; Huang, Y. Diverse Antibacterial Treatments beyond Antibiotics for Diabetic Foot Ulcer Therapy. Adv. Healthc. Mater. 2023, 12, e2300375. [Google Scholar] [CrossRef]
- Boniakowski, A.E.; Kimball, A.S.; Jacobs, B.N.; Kunkel, S.L.; Gallagher, K.A. Macrophage-Mediated Inflammation in Normal and Diabetic Wound Healing. J. Immunol. 2017, 199, 17–24. [Google Scholar] [CrossRef]
- Balachandran, A.; Choi, S.B.; Beata, M.M.; Malgorzata, J.; Froemming, G.R.A.; Lavilla, C.A., Jr.; Billacura, M.P.; Siyumbwa, S.N.; Okechukwu, P.N. Antioxidant, Wound Healing Potential and In Silico Assessment of Naringin, Eicosane and Octacosane. Molecules 2023, 28, 1043. [Google Scholar] [CrossRef]
- Masood, N.; Ahmed, R.; Tariq, M.; Ahmed, Z.; Masoud, M.S.; Ali, I.; Asghar, R.; Andleeb, A.; Hasan, A. Silver nanoparticle impregnated chitosan-PEG hydrogel enhances wound healing in diabetes induced rabbits. Int. J. Pharm. 2019, 559, 23–36. [Google Scholar] [CrossRef]
- Ye, H.; Cheng, J.; Yu, K. In situ reduction of silver nanoparticles by gelatin to obtain porous silver nanoparticle/chitosan composites with enhanced antimicrobial and wound-healing activity. Int. J. Biol. Macromol. 2019, 121, 633–642. [Google Scholar] [CrossRef] [PubMed]
- Xu, Q.; Chang, M.; Zhang, Y.; Wang, E.; Xing, M.; Gao, L.; Huan, Z.; Guo, F.; Chang, J. PDA/Cu Bioactive Hydrogel with “Hot Ions Effect” for Inhibition of Drug-Resistant Bacteria and Enhancement of Infectious Skin Wound Healing. ACS Appl. Mater. Interfaces 2020, 12, 31255–31269. [Google Scholar] [CrossRef] [PubMed]
- Song, R.; Zheng, J.; Liu, Y.; Tan, Y.; Yang, Z.; Song, X.; Yang, S.; Fan, R.; Zhang, Y.; Wang, Y. A natural cordycepin/chitosan complex hydrogel with outstanding self-healable and wound healing properties. Int. J. Biol. Macromol. 2019, 134, 91–99. [Google Scholar] [CrossRef] [PubMed]
- Chen, Z.; Wu, H.; Wang, H.; Zaldivar-Silva, D.; Agüero, L.; Liu, Y.; Zhang, Z.; Yin, Y.; Qiu, B.; Zhao, J.; et al. An injectable anti-microbial and adhesive hydrogel for the effective noncompressible visceral hemostasis and wound repair. Mater. Sci. Eng. C Mater. Biol. Appl. 2021, 129, 112422. [Google Scholar] [CrossRef] [PubMed]
- Bai, Q.; Gao, Q.; Hu, F.; Zheng, C.; Chen, W.; Sun, N.; Liu, J.; Zhang, Y.; Wu, X.; Lu, T. Chitosan and hyaluronic-based hydrogels could promote the infected wound healing. Int. J. Biol. Macromol. 2023, 232, 123271. [Google Scholar] [CrossRef] [PubMed]
- Chen, H.; Zeng, J.; Wang, B.; Cheng, Z.; Xu, J.; Gao, W.; Chen, K. Structural characterization and antioxidant activities of Bletilla striata polysaccharide extracted by different methods. Carbohydr. Polym. 2021, 266, 118149. [Google Scholar] [CrossRef]
- Chen, Z.; Cheng, L.; He, Y.; Wei, X. Extraction, characterization, utilization as wound dressing and drug delivery of Bletilla striata polysaccharide: A review. Int. J. Biol. Macromol. 2018, 120, 2076–2085. [Google Scholar] [CrossRef]
- Zhu, B.; Cheng, W.; Zhao, K.; Hu, Z.; Zhou, F.; Zhou, M.; Qian, C.; Ding, Z. Multifunctional composite dressings based on Bletilla striata polysaccharide and zeolite for rapid hemostatic and accelerated wound healing. J. Mater. Sci. 2023, 58, 5427–5443. [Google Scholar] [CrossRef]
- Cheng, W.; Zhou, F.; Zhu, B.; Ding, X.; Lu, J.; Qian, C.; Ye, X.; Ding, Z. Characterization and evaluation of Bletilla striata polysaccharide/ethanol extract composite multifunctional sponges. Mater. Des. 2021, 206, 109806. [Google Scholar] [CrossRef]
- Li, Z.; Wang, Y.; Xu, Q.; Ma, J.; Li, X.; Yan, J.; Tian, Y.; Wen, Y.; Chen, T. Berberine and health outcomes: An umbrella review. Phytother. Res. 2023, 37, 2051–2066. [Google Scholar] [CrossRef]
- Guo, H.H.; Shen, H.R.; Wang, L.L.; Luo, Z.G.; Zhang, J.L.; Zhang, H.J.; Gao, T.L.; Han, Y.X.; Jiang, J.D. Berberine is a potential alternative for metformin with good regulatory effect on lipids in treating metabolic diseases. Biomed. Pharmacother. 2023, 163, 114754. [Google Scholar] [CrossRef] [PubMed]
- Zhu, W.; Liu, Y.Q.; Liu, P.; Cao, J.; Shen, A.G.; Chu, P.K. Blood-Glucose-Depleting Hydrogel Dressing as an Activatable Photothermal/Chemodynamic Antibacterial Agent for Healing Diabetic Wounds. ACS Appl. Mater. Interfaces 2023, 15, 20. [Google Scholar] [CrossRef] [PubMed]
- Asadi, N.; Pazoki-Toroudi, H.; Del Bakhshayesh, A.R.; Akbarzadeh, A.; Davaran, S.; Annabi, N. Multifunctional hydrogels for wound healing: Special focus on biomacromolecular based hydrogels. Int. J. Biol. Macromol. 2021, 170, 728–750. [Google Scholar] [CrossRef] [PubMed]
- Gao, D.; Zhang, Y.; Bowers, D.T.; Liu, W.; Ma, M. Functional hydrogels for diabetic wound management. APL Bioeng. 2021, 5, 031503. [Google Scholar] [CrossRef]
- Norahan, M.H.; Pedroza-Gonzalez, S.C.; Sanchez-Salazar, M.G.; Alvarez, M.M.; Trujillo de Santiago, G. Structural and biological engineering of 3D hydrogels for wound healing. Bioact. Mater. 2023, 24, 197–235. [Google Scholar] [CrossRef]
- Verma, J.; Kanoujia, J.; Parashar, P.; Tripathi, C.B.; Saraf, S.A. Wound healing applications of sericin/chitosan-capped silver nanoparticles incorporated hydrogel. Drug Deliv. Transl. Res. 2017, 7, 77–88. [Google Scholar] [CrossRef]
- Huang, Y.; Shi, F.; Wang, L.; Yang, Y.; Khan, B.M.; Cheong, K.L.; Liu, Y. Preparation and evaluation of Bletilla striata polysaccharide/carboxymethyl chitosan/Carbomer 940 hydrogel for wound healing. Int. J. Biol. Macromol. 2019, 132, 729–737. [Google Scholar] [CrossRef]
- He, J.; Ye, G.; Ma, H.; Jia, S.; Ma, J.; Lv, J.; Jia, D.; Song, Y.; Liu, F.; Li, P.; et al. Multifunctional Bletilla striata polysaccharide/copper/peony leaf sponge for the full-stage wound healing. Int. J. Biol. Macromol. 2023, 240, 124487. [Google Scholar] [CrossRef]
- Hu, H.; Luo, F.; Zhang, Q.; Xu, M.; Chen, X.; Liu, Z.; Xu, H.; Wang, L.; Ye, F.; Zhang, K.; et al. Berberine coated biocomposite hemostatic film based alginate as absorbable biomaterial for wound healing. Int. J. Biol. Macromol. 2022, 209, 1731–1744. [Google Scholar] [CrossRef]
- Wang, H.; Liu, Y.; Cai, K.; Zhang, B.; Tang, S.; Zhang, W.; Liu, W. Antibacterial polysaccharide-based hydrogel dressing containing plant essential oil for burn wound healing. Burn. Trauma 2021, 9, tkab041. [Google Scholar] [CrossRef]
- Zhang, H.Y.; Wang, K.T.; Zhang, Y.; Cui, Y.L.; Wang, Q. A self-healing hydrogel wound dressing based on oxidized Bletilla striata polysaccharide and cationic gelatin for skin trauma treatment. Int. J. Biol. Macromol. 2023, 253, 127189. [Google Scholar] [CrossRef] [PubMed]
- Zhou, Z.; Xiao, J.; Guan, S.; Geng, Z.; Zhao, R.; Gao, B. A hydrogen-bonded antibacterial curdlan-tannic acid hydrogel with an antioxidant and hemostatic function for wound healing. Carbohydr. Polym. 2022, 285, 119235. [Google Scholar] [CrossRef] [PubMed]
- Yang, R.; Xue, W.; Liao, H.; Wu, F.; Guo, H.; Zhang, W.; Wang, P.; Tan, X.; Xu, H.; Chi, B. Injectable polylysine and dextran hydrogels with robust antibacterial and ROS-scavenging activity for wound healing. Int. J. Biol. Macromol. 2022, 223, 950–960. [Google Scholar] [CrossRef] [PubMed]
- Jia, G.; Li, Z.; Le, H.; Jiang, Z.; Sun, Y.; Liu, H.; Chang, F. Green tea derivative-based hydrogel with ROS-scavenging property for accelerating diabetic wound healing. Mater. Des. 2023, 225, 111452. [Google Scholar] [CrossRef]
- Yang, Z.; Huang, R.; Zheng, B.; Guo, W.; Li, C.; He, W.; Wei, Y.; Du, Y.; Wang, H.; Wu, D.; et al. Highly Stretchable, Adhesive, Biocompatible, and Antibacterial Hydrogel Dressings for Wound Healing. Adv. Sci. 2021, 8, 2003627. [Google Scholar] [CrossRef]
- Yang, J.; Zeng, W.; Xu, P.; Fu, X.; Yu, X.; Chen, L.; Leng, F.; Yu, C.; Yang, Z. Glucose-responsive multifunctional metal-organic drug-loaded hydrogel for diabetic wound healing. Acta Biomater. 2022, 140, 206–218. [Google Scholar] [CrossRef]
- Chang, W.; Chen, L.; Hatch, G.M. Berberine as a therapy for type 2 diabetes and its complications: From mechanism of action to clinical studies. Biochem. Cell Biol. 2015, 93, 479–486. [Google Scholar] [CrossRef]
- Cok, A.; Plaisier, C.; Salie, M.J.; Oram, D.S.; Chenge, J.; Louters, L.L. Berberine acutely activates the glucose transport activity of GLUT1. Biochimie 2011, 93, 1187–1192. [Google Scholar] [CrossRef]
- He, X.; Wang, X.; Fang, J.; Zhao, Z.; Huang, L.; Guo, H.; Zheng, X. Bletilla striata: Medicinal uses, phytochemistry and pharmacological activities. J. Ethnopharmacol. 2017, 195, 20–38. [Google Scholar] [CrossRef]
- Liu, J.; Qu, M.; Wang, C.; Xue, Y.; Huang, H.; Chen, Q.; Sun, W.; Zhou, X.; Xu, G.; Jiang, X. A Dual-Cross-Linked Hydrogel Patch for Promoting Diabetic Wound Healing. Small 2022, 18, e2106172. [Google Scholar] [CrossRef]
- Wang, G.; Yang, F.; Zhou, W.; Xiao, N.; Luo, M.; Tang, Z. The initiation of oxidative stress and therapeutic strategies in wound healing. Biomed. Pharmacother. 2023, 157, 114004. [Google Scholar] [CrossRef]
- Qi, X.; Tong, X.; You, S.; Mao, R.; Cai, E.; Pan, W.; Zhang, C.; Hu, R.; Shen, J. Mild Hyperthermia-Assisted ROS Scavenging Hydrogels Achieve Diabetic Wound Healing. ACS Macro Lett. 2022, 11, 861–867. [Google Scholar] [CrossRef] [PubMed]
- Wei, C.; Tang, P.; Tang, Y.; Liu, L.; Lu, X.; Yang, K.; Wang, Q.; Feng, W.; Shubhra, Q.T.H.; Wang, Z.; et al. Sponge-Like Macroporous Hydrogel with Antibacterial and ROS Scavenging Capabilities for Diabetic Wound Regeneration. Adv. Healthc. Mater. 2022, 11, e2200717. [Google Scholar] [CrossRef] [PubMed]
- Hu, B.; Gao, M.; Boakye-Yiadom, K.O.; Ho, W.; Yu, W.; Xu, X.; Zhang, X.Q. An intrinsically bioactive hydrogel with on-demand drug release behaviors for diabetic wound healing. Bioact. Mater. 2021, 6, 4592–4606. [Google Scholar] [CrossRef]
- Yin, X.; Fan, X.; Zhou, Z.; Li, Q. Encapsulation of berberine decorated ZnO nano-colloids into injectable hydrogel using for diabetic wound healing. Front. Chem. 2022, 10, 964662. [Google Scholar] [CrossRef]
- Cheng, C.; Zhong, H.; Zhang, Y.; Gao, X.; Wang, J.; Liu, J.; Han, X. Bacterial responsive hydrogels based on quaternized chitosan and GQDs-epsilon-PL for chemo-photothermal synergistic anti-infection in diabetic wounds. Int. J. Biol. Macromol. 2022, 210, 377–393. [Google Scholar] [CrossRef] [PubMed]
- Wang, S.; Hou, Y.; Zhang, S.; Li, J.; Chen, Q.; Yu, M.; Li, W. Sustained antibacterial activity of berberine hydrochloride loaded supramolecular organoclay networks with hydrogen-bonding junctions. J. Mater. Chem. B 2018, 6, 4972–4984. [Google Scholar] [CrossRef]
- Xie, Y.; Zhang, Q.; Zheng, W.; Jiang, X. Small Molecule-Capped Gold Nanoclusters for Curing Skin Infections. ACS Appl. Mater. Interfaces 2021, 13, 35306–35314. [Google Scholar] [CrossRef]

| Sample Code | BSP (g) | BER (g) | Carbomer 940 (CMB 940) (g) | Water (mL) |
|---|---|---|---|---|
| HBSP/BER1 | 1.00 | 0.05 | 0.25 | 50 |
| HBSP/BER2 | 1.00 | 0.25 | 0.25 | 50 |
| LBSP/BER1 | 0.50 | 0.25 | 0.25 | 50 |
| LBSP/BER2 | 0.50 | 0.125 | 0.25 | 50 |
| Materials | Absorption Peak | Chemical Group |
|---|---|---|
| BSP | 3420 cm−1 | -OH |
| 2819 cm−1 | -CH | |
| 1732 cm−1 | -COOH | |
| 1126 cm−1 | -C-O-C- | |
| 872 cm−1 | β-glucose | |
| 764 cm−1 | Mannose residues | |
| BER | 3420 cm−1 | -OH |
| 2845 cm−1 | -CH | |
| 1597 cm−1, 1507 cm−1 | Benzene ring skeleton | |
| CBM940 | 3446 cm−1 | -OH |
| 2959 cm−1 | -CH | |
| 1716 cm−1 | -COOH |
Disclaimer/Publisher’s Note: The statements, opinions and data contained in all publications are solely those of the individual author(s) and contributor(s) and not of MDPI and/or the editor(s). MDPI and/or the editor(s) disclaim responsibility for any injury to people or property resulting from any ideas, methods, instructions or products referred to in the content. |
© 2023 by the authors. Licensee MDPI, Basel, Switzerland. This article is an open access article distributed under the terms and conditions of the Creative Commons Attribution (CC BY) license (https://creativecommons.org/licenses/by/4.0/).
Share and Cite
Hu, Z.; Zhao, K.; Chen, X.; Zhou, M.; Chen, Y.; Ye, X.; Zhou, F.; Ding, Z.; Zhu, B. A Berberine-Loaded Bletilla striata Polysaccharide Hydrogel as a New Medical Dressing for Diabetic Wound Healing. Int. J. Mol. Sci. 2023, 24, 16286. https://doi.org/10.3390/ijms242216286
Hu Z, Zhao K, Chen X, Zhou M, Chen Y, Ye X, Zhou F, Ding Z, Zhu B. A Berberine-Loaded Bletilla striata Polysaccharide Hydrogel as a New Medical Dressing for Diabetic Wound Healing. International Journal of Molecular Sciences. 2023; 24(22):16286. https://doi.org/10.3390/ijms242216286
Chicago/Turabian StyleHu, Zhengbo, Kai Zhao, Xingcan Chen, Mingyuan Zhou, Yuchi Chen, Xiaoqing Ye, Fangmei Zhou, Zhishan Ding, and Bingqi Zhu. 2023. "A Berberine-Loaded Bletilla striata Polysaccharide Hydrogel as a New Medical Dressing for Diabetic Wound Healing" International Journal of Molecular Sciences 24, no. 22: 16286. https://doi.org/10.3390/ijms242216286
APA StyleHu, Z., Zhao, K., Chen, X., Zhou, M., Chen, Y., Ye, X., Zhou, F., Ding, Z., & Zhu, B. (2023). A Berberine-Loaded Bletilla striata Polysaccharide Hydrogel as a New Medical Dressing for Diabetic Wound Healing. International Journal of Molecular Sciences, 24(22), 16286. https://doi.org/10.3390/ijms242216286
